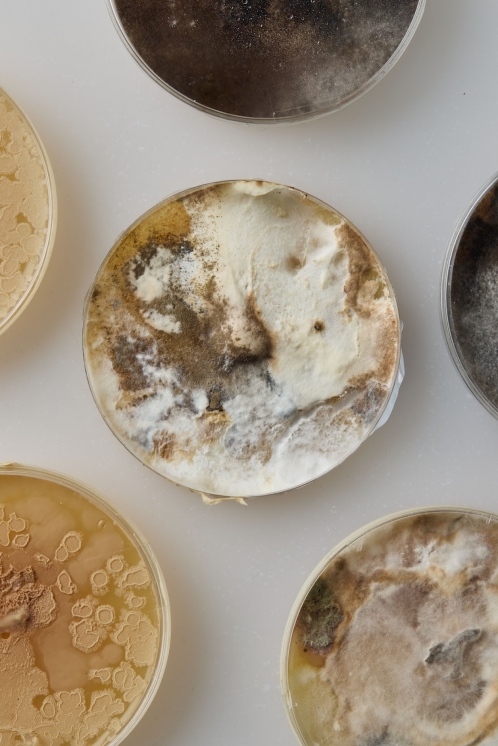
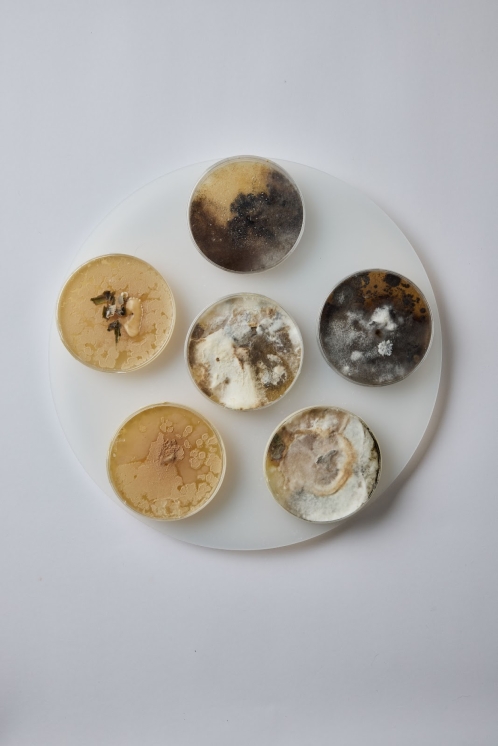
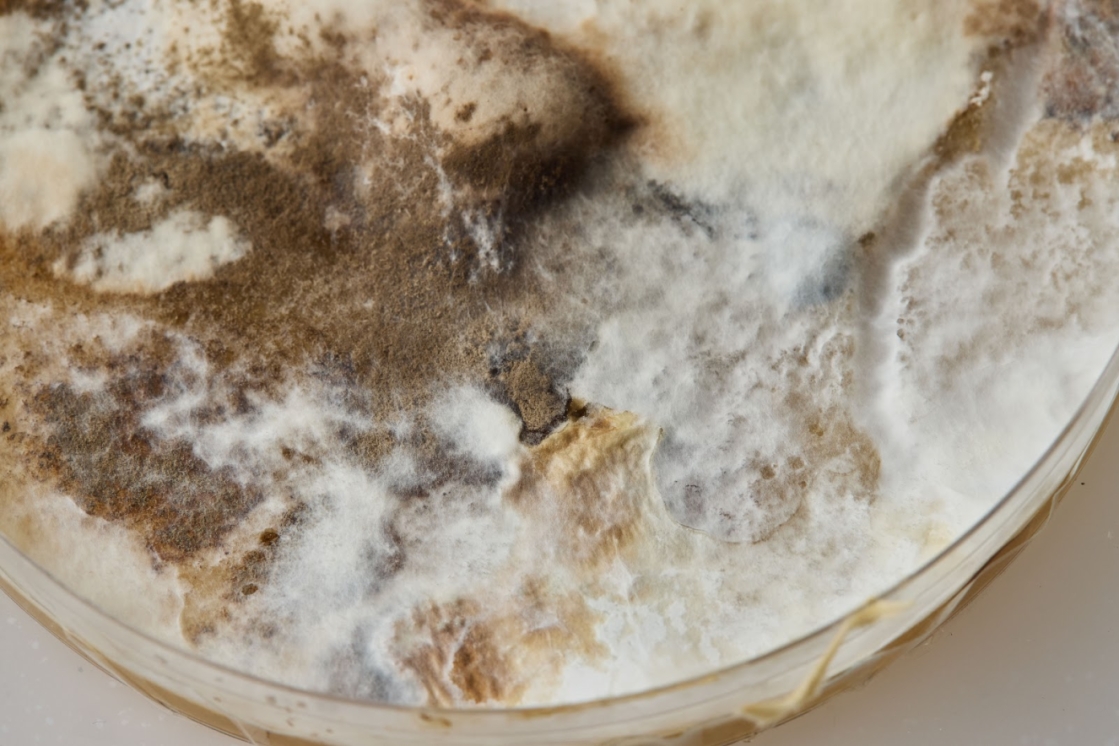
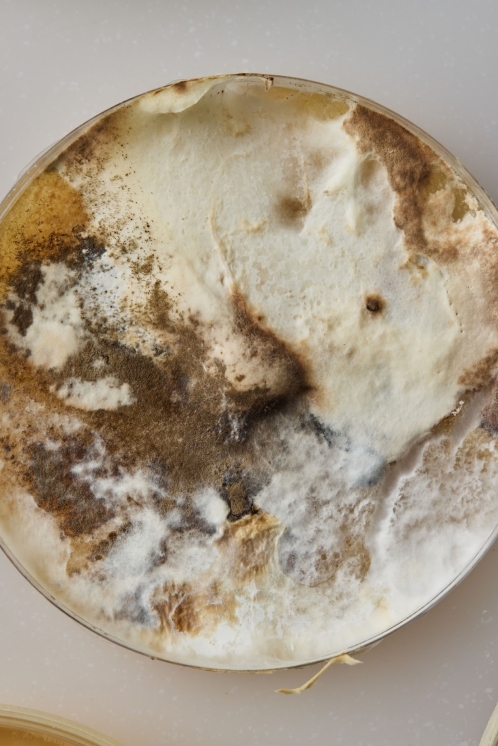

School of Creative
Industries
Ou Xiaoran Quinn
Quinn has a background in fine arts, and was previously engaged in artistic practice and exhibition curation. Transitioning into art psychotherapy training, she seeks to explore the potential of art in fostering well-being across diverse groups and populations.
While pursuing her MA Art Therapy degree at LASALLE College of the Arts, Quinn gained clinical experience by providing therapeutic services in elderly care facilities and institutions supporting children with long-term illnesses.
In her personal art practice, she investigates the symbiotic relationship between individuals and society. By experimenting with the unique properties of various materials, she explores psychological dynamics, fostering interaction between audiences and her works. She favours mixed media as a means to weave personal narratives into broader social contexts, creating immersive and thought-provoking experiences.